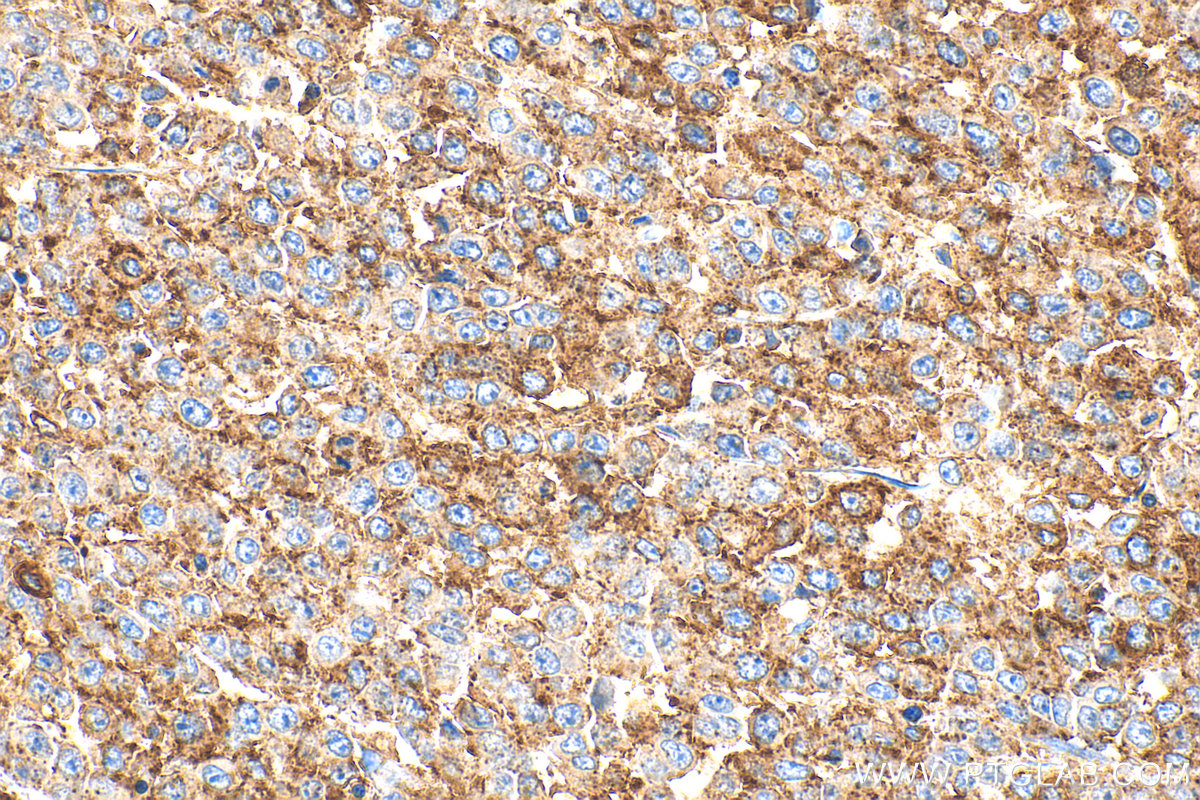
Immunohistochemistry (IHC) staining of human colon cancer tissue using MX1 Polyclonal antibody (13750-1-AP)

Tested Applications
| Positive WB detected in | IFN alpha treated A549 cells, mouse lung tissue |
| Positive IP detected in | IFN alpha treated A549 cells |
| Positive IHC detected in | human tonsillitis tissue, human colon cancer tissue, human lung cancer tissue Note: suggested antigen retrieval with TE buffer pH 9.0; (*) Alternatively, antigen retrieval may be performed with citrate buffer pH 6.0 |
| Positive IF/ICC detected in | A549 cells |
| Positive FC (Intra) detected in | A549 cells |
Recommended dilution
| Application | Dilution |
|---|---|
| Western Blot (WB) | WB : 1:500-1:1000 |
| Immunoprecipitation (IP) | IP : 0.5-4.0 ug for 1.0-3.0 mg of total protein lysate |
| Immunohistochemistry (IHC) | IHC : 1:500-1:2000 |
| Immunofluorescence (IF)/ICC | IF/ICC : 1:50-1:500 |
| Flow Cytometry (FC) (INTRA) | FC (INTRA) : 0.40 ug per 10^6 cells in a 100 µl suspension |
| It is recommended that this reagent should be titrated in each testing system to obtain optimal results. | |
| Sample-dependent, Check data in validation data gallery. | |
Published Applications
| KD/KO | See 5 publications below |
| WB | See 77 publications below |
| IHC | See 10 publications below |
| IF | See 13 publications below |
| IP | See 1 publications below |
Product Information
13750-1-AP targets MX1 in WB, IHC, IF/ICC, FC (Intra), IP, ELISA applications and shows reactivity with human, mouse samples.
| Tested Reactivity | human, mouse |
| Cited Reactivity | human, mouse, pig, canine, monkey, chicken, hamster, pavo cristatus, macaque |
| Host / Isotype | Rabbit / IgG |
| Class | Polyclonal |
| Type | Antibody |
| Immunogen |
CatNo: Ag4692 Product name: Recombinant human MX1 protein Source: e coli.-derived, PGEX-4T Tag: GST Domain: 312-662 aa of BC032602 Sequence: LLEEGKATVPCLAEKLTSELITHICKSLPLLENQIKETHQRITEELQKYGVDIPEDENEKMFFLIDKINAFNQDITALMQGEETVGEEDIRLFTRLRHEFHKWSTIIENNFQEGHKILSRKIQKFENQYRGRELPGFVNYRTFETIVKQQIKALEEPAVDMLHTVTDMVRLAFTDVSIKNFEEFFNLHRTAKSKIEDIRAEQEREGEKLIRLHFQMEQIVYCQDQVYRGALQKVREKELEEEKKKKSWDFGAFQSSSATDSSMEEIFQHLMAYHQEASKRISSHIPLIIQFFMLQTYGQQLQKAMLQLLQDKDTYSWLLKERSDTSDKRKFLKERLARLTQARRRLAQFPG Predict reactive species |
| Full Name | Myxovirus resistance protein 1 |
| Calculated Molecular Weight | 662 aa, 76 kDa |
| Observed Molecular Weight | 76 kDa |
| GenBank Accession Number | BC032602 |
| Gene Symbol | MX1 |
| Gene ID (NCBI) | 4599 |
| RRID | AB_2266768 |
| Conjugate | Unconjugated |
| Form | Liquid |
| Purification Method | Antigen affinity purification |
| UNIPROT ID | P20591 |
| Storage Buffer | PBS with 0.02% sodium azide and 50% glycerol, pH 7.3. |
| Storage Conditions | Store at -20°C. Stable for one year after shipment. Aliquoting is unnecessary for -20oC storage. 20ul sizes contain 0.1% BSA. |
Background Information
Mx1 (also known as MxA) is a GTPase that belongs to the Mx family of proteins, which are ubiquitous in eukaryotes and involved in the immune response to viral infections. The human Mx1 is localized in the cytoplasm interfering with the translation of viral proteins, whereas the mouse Mx1 accumulates in the nucleus and inhibits the primary transcription of viral RNA. Mx1 expression is induced by treatment with α/β IFN. This antibody can recognize the endogenous Mx1 protein in several tissues like lung and spleen.
Protocols
| Product Specific Protocols | |
|---|---|
| FC protocol for MX1 antibody 13750-1-AP | Download protocol |
| IF protocol for MX1 antibody 13750-1-AP | Download protocol |
| IHC protocol for MX1 antibody 13750-1-AP | Download protocol |
| IP protocol for MX1 antibody 13750-1-AP | Download protocol |
| WB protocol for MX1 antibody 13750-1-AP | Download protocol |
| Standard Protocols | |
|---|---|
| Click here to view our Standard Protocols |
Publications
| Species | Application | Title |
|---|---|---|
Cell Host Microbe NRAV, a long noncoding RNA, modulates antiviral responses through suppression of interferon-stimulated gene transcription. | ||
Nat Commun Large-scale and high-resolution mass spectrometry-based proteomics profiling defines molecular subtypes of esophageal cancer for therapeutic targeting. | ||
Hepatology MxA inhibits hepatitis B virus replication by interaction with hepatitis B core antigen. | ||
Nat Commun Repeated semen exposure decreases cervicovaginal SIVmac251 infection in rhesus macaques. | ||
Reviews
The reviews below have been submitted by verified Proteintech customers who received an incentive for providing their feedback.
FH Hannah (Verified Customer) (09-21-2020) | Used for western blot on human fibroblasts -/+ interferon treatment, detected single band only in IFN treated samples.
![]() |